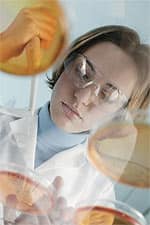
Experimental Studies

Life Extension Magazine®
Few lay people understand that one of the reasons chemotherapy does not cure more cancers is that its inherent toxicity limits the dosage that can be administered. What this means is that even if the cancer is slowly being eradicated by the chemo drugs, the damage inflicted on healthy cells can be so severe that chemotherapy must be discontinued. A common side effect cancer victims face is chemotherapy-induced immune suppression that leaves patients susceptible to life-threatening infections. Fortunately, research suggests that coenzyme Q10 (CoQ10) can offer critical support for those challenged with cancer, including improving the tolerability of chemotherapy and lessening its adverse impact on immune function. In addition, tantalizing evidence suggests that CoQ10 may help chemotherapy drugs more effectively battle cancer via several fascinating mechanisms. Here, we’ll explore CoQ10’s importance in combating cancer. Coenzyme Q10 BasicsBest known in medicine today for its vital contributions to heart and brain health,1 exciting new discoveries point to broad and novel roles for CoQ10 as a “chemoprotectant” with tremendous promise as an adjuvant therapy in cancer treatment.2-5 Early recognition of CoQ10’s potential as a cellular protectant came from the oncology laboratory of researchers studying the toxic effects of a potent chemotherapy drug, adriamycin (doxorubicin).6 Adriamycin is in the anthracycline class that kills cancer cells by damaging their DNA. At the high doses used in cancer treatment, however, adriamycin also interferes with mitochondria in healthy cells,7 causing damage to heart muscle that limits the drug’s usefulness and safety. Remarkably, when researchers treated laboratory rats first with CoQ10 and then with adriamycin, they found survival rates of 80-86%, compared with just 36-42% in animals receiving the drug alone without the supplement.6 Italian researchers confirmed this effect in a particularly vulnerable group of human patients—children with cancer.8 One group of children with leukemia or lymphoma received chemotherapy with anthra-cycline drugs plus CoQ10, while the other group was treated without the supplement. The researchers studied the children’s heart function using echocardiography, a means of directly viewing the beating heart and its structures with ultrasound. Under the punishing effects of the drugs, all children suffered some loss of cardiac function, but those in the CoQ10-supplemented group showed significantly less impairment than those in the drug-only group. The treating physicians concluded that their data demonstrated “a protective effect of CoQ10 on cardiac function during therapy.” Inflammation, Oxidative Stress, and Genetic Damage – The Deadly CycleTo understand the fundamental role that CoQ10 can play in cancer prevention and management, it’s important to recognize the intimate relationships between oxidant damage, inflammation, and the processes that initiate and promote cancer growth. Throughout life, a build-up of free radical damaged components occurs within cells, particularly during times of severe oxidant stress, such as disease and injury.9
Tissue damaged by free radicals triggers a protective inflammatory response through the release of chemical signals called cytokines and chemokines. Beneficial at first and in controlled amounts, these “mediators of inflammation” eventually produce new tissue damage. With time, this inflammation-induced cycle of destruction contributes to DNA damage.9 Cancer can occur when at least two conditions are met.10 First, DNA must become sufficiently damaged that a cell loses control of its own growth-regulating mechanisms (this process is called initiation of cancer). The next step, promotion, can occur when “cross-talk” between normal immune cells patrolling for cancerous cells becomes garbled by the chemical storm produced by inflammation.11 This disruption in cellular communication can allow tumor cells to proliferate. Finally, reactive oxygen species interfere with fundamental cellular controls that normally cause the programmed cell death of cancerous cells in the process known as apoptosis.11,12 By interfering with apoptosis, inflammatory cytokines render cancer cells resistant not only to natural control mechanisms but even to cancer-killing chemotherapy drugs. CoQ10 and CancerCancer is both the result and a significant cause of free-radical damage related to inflammation. A growing awareness of this critical and intimate association has led scientists to explore ways of controlling cancer growth by limiting free-radical damage. This line of thinking is a result not only of our progress in understanding how cancer develops, but also of our struggle to control the disastrous effects of chemotherapy drugs on healthy tissues. Given its strong performance as a tissue-protecting antioxidant molecule that promotes cardiovascular and brain health, it’s not surprising that cutting-edge medical researchers turned to CoQ10 as a possible means of preventing chemotherapy-related damage. What might be more surprising is that this versatile nutrient seems to actually improve the cancer-killing impact of the chemotherapy drugs themselves! Preliminary FindingsCoQ10 became part of the oncologist’s arsenal three decades ago when animal studies demonstrated how it could protect against the burst of free-radical release resulting from adriamycin treatment of various cancers.6,13 Within a year of its first use in that setting, however, alert scientists began to notice that CoQ10 was having an independent beneficial effect—it was helping to energize immune system cells that had been suppressed by cancer, restoring their ability to fight back by attacking the cancer cells themselves (remember that the immune system is a powerful defense against cancer metastasis).14-16 This “immunostimulatory” effect was demonstrated by Japanese researchers when they used carcinogenic chemicals to produce colon cancer in rats, followed by treatment with CoQ10 or other immunostimulants.17 As expected, none of the immune-stimulating treatments alone prevented colon cancer from developing—but all of them significantly reduced the number of tumors and also prevented their invasion of other tissues.
As CoQ10 began to be used to reduce the side effects of chemotherapy, alert scientists from the Institute for Biomedical Research at the University of Texas, Austin, began to assemble data on cancer survival rates in humans; by 1993, they found that over the preceding 25 years, patients with a number of cancer and blood-related conditions showed “striking” responses to therapy with CoQ10.18 Enhanced immune function was shown in other studies examined by this group of researchers, and they were able to document a total of 10 cases of unexpected survival of cancer patients treated with CoQ10 supplements. In the dramatically understated words of the lead investigator, “these results now justify systematic protocols.” Several years later, the first fruits of such protocols began to be evident. The same Texas research group reported in 1997 on blood levels of CoQ10 in 116 cancer patients.19 Among breast cancer patients, 39% had CoQ10 levels below 0.6 mcg/mL; among healthy people in the same study only 25% had levels this low, a significant difference. (Healthy people taking CoQ10 supplements strive for CoQ10 blood levels of 2-3 mcg/mL, which demonstrates how severely deficient these breast cancer patients were who averaged only 0.6 mcg/mL.) In patients with multiple myeloma, as many as 53% of patients had low CoQ10 levels. Other preliminary studies reported that CoQ10 might inhibit some of the tumor-associated cytokines that contribute to cancer proliferation.20 Carefully designed experimental studies soon followed, which provided more solid evidence of how CoQ10 might improve cancer survival independently of its proven ability to mitigate the devastating effects of chemotherapy.
Experimental StudiesRecognizing that CoQ10 achieves some of its protective effects by quenching chemotherapy-induced free-radical damage in mitochondria,7 biochemical researchers at the Post Graduate Institute of Basic Medical Sciences in Madras, India, looked for ways to protect mitochondrial function in cancer patients even before chemotherapy was begun.21 They took this approach because cancer results in markedly abnormal energy management, in which production of the vital cellular energy molecule adenosine triphosphate (ATP) is diminished. Without sufficient ATP, patients develop cachexia, the classic wasting we associate with cancer and other chronic illnesses. The Madras researchers wondered if protecting healthy cell mitochondrial ATP production lines with “energy-modulating” vitamins including CoQ10 could liberate more energy, giving cancer victims more resources to fight and control the cancer itself. To make this determination, the scientists induced mammary (breast) cancer in laboratory rats using a powerful chemical carcinogen. They then treated the animals with a combination comprising riboflavin, niacin, and CoQ10, or no supplement (controls) for 28 days. The mitochondria of the untreated cancer-bearing animals showed significantly decreased activity of the enzyme systems vital to extraction of energy and production of ATP, as was expected. Rats supplemented with the “energy-modulating” vitamins, however, showed restoration of those enzyme activities, making more energy available to the animals. This study was one of the first to show beneficial effects of CoQ10 in managing cancer independently of reducing chemotherapy side effects.
For researchers at the prestigious National Cancer Center Research Institute in Tokyo, those findings triggered another intriguing line of study. If CoQ10 reduced mitochondrial injury and improved the antioxidant status of the cell, could the ubiquitous nutrient actually prevent cancers from arising and proliferating? To find out, the scientists induced colon cancer in laboratory rats using a potent toxin called azoxymethane.22 The animals were fed either an unsupplemented control diet, or a diet containing low and medium doses of CoQ10, beginning just one day before the first dose of the carcinogen and continuing for four weeks. The researchers then sought evidence of early cancerous changes similar to those physicians look for during a colonoscopy, such as abnormal crypts. The results were remarkable—supplemented animals had reductions in abnormal crypts by up to nearly one-third compared with control animals. Perhaps even more strikingly, the abnormal crypts in supplemented animals contained significantly fewer abnormal cells than in the control group, suggesting that even when cancer did arise under this powerful stimulus, CoQ10 held it in check. Finally, in the supplemented animals, the number of crypts producing abnormal mucus (another early sign of colon cancer) was reduced to less than half that found in unsupplemented animals. The report concluded that “CoQ10 may be an effective chemopreventive agent against colon carcinogenesis.” Back at the Department of Medical Biochemistry in Madras, researchers sought ways to prevent cancer cells from proliferating once formed. Given the tremendous odds in favor of DNA damage over a lifetime and the body’s natural ability to find and kill cancer cells with normal immunity, this strategy of “secondary prevention” is one that is being widely explored. In this case, the researchers studied the combination of CoQ10 and tamoxifen, a potent chemotherapy drug with its own antioxidant effects but significant side effects when given alone.10 They induced mammary carcinomas (breast cancers) in laboratory rats, and then treated them with various combinations of CoQ10 and tamoxifen. As expected, in control animals that received no therapy, antioxidant capacity dropped precipitously as their tumors developed. Supplemented animals, however, saw their antioxidant activities significantly restored, with inhibition of progression of their cancers. The same research group then investigated a combination of riboflavin, niacin, and CoQ10, again in combination with tamoxifen in laboratory rats with chemically induced breast cancers.23 This time they took a much closer molecular look at the events inside a tumor cell, and at the effects of the antioxidants on those events. After inducing breast malignancies in female rats, the researchers supplemented most of the animals with the CoQ10-containing combination, studying oxidation products and enzyme activities within the cancer cells. Astonishingly, the supplements restored levels of all antioxidant systems in the cells to nearly normal values! And it wasn’t just a numbers game: antitumor activity was enhanced through increased production of tumor-suppressor genes—natural proteins that prevent aberrant cellular proliferation. | ||||||
Human StudiesFrustratingly, and often tragically, compelling data from animal studies is only slowly translated into human clinical trials—arguably at considerable cost in human suffering. This has been the situation with CoQ10 until quite recently. In fact, Life Extension enlisted a ‘call to action’ in early 200624 for increased support of human trials using various doses of CoQ10. Fortunately, that call has been heard, and convincing data from properly conducted human trials are now emerging.
Several small human trials were conducted in the 1990s, but with a regrettable lack of enthusiasm in the medical community.25 For example, the immune-stimulating powers of CoQ10 were explored by the same Austin biochemists who later attained prominence as a result of their fundamental work with the nutrient.26 When they gave CoQ10 and vitamin B6 (pyridoxine) to human subjects and measured levels of immunoglobulin G (an important antibody protein in the human immune system), they noted significant increases. Intriguingly, they also found that blood levels of the “T4-helper” cell line also increased, as did the ratio of T-helper/T-suppressor cells, indicating a significant boost in subjects’ immunologic protection against viruses and the abnormal cell surface markers associated with cancer. In 1994, partial remission of breast cancer was noted in a group of patients in Denmark following their supplementation with CoQ10 along with other antioxidants and essential fatty acids.27 In this groundbreaking study, 32 women with breast cancer categorized as high risk, because of the spread of their tumor to the lymph nodes, took supplements of vitamins C and E plus selenium, essential fatty acids, and CoQ10 (90 mg/day). The researchers took this “combinatorial” approach using their knowledge that multiple factors act synergistically to initiate and promote cancer growth. Based on this principle the researchers hypothesized that the synergistic effects of multiple components should also be tested to evaluate their anticancer effects together. All patients in this study had already undergone surgery but were known to have residual tumor remaining. Dramatically, there were zero deaths during the study period, despite an expected mortality rate of four patients. No patient showed signs of developing new metastases, and all patients reported an improvement in the quality of life. Still more remarkably, in that same Danish study, was the finding that six of the 32 women actually showed partial tumor regression (that is, not only did remaining tumors not grow, but they actually became smaller). Encouraged, the researchers increased the daily dose of CoQ10 in one patient to 390 mg—a month later, she had no tumor detectable on physical examination, and by the end of the following month, the tumor was entirely gone on her mammogram. The investigators then raised the dose in a second patient as well—the researchers reported that, “after three months, the patient was in excellent clinical condition and there was no residual tumor tissue.” Concluding this stunning report, the scientists noted that CoQ10’s “bioenergetic activity” (that is, its ability to protect cells from oxidant damage and to make more energy available for healthy function) may be the dominant mechanism causing these dramatic regressions of breast cancer.28 The Indian researchers in Madras also took their knowledge and skills from the laboratory to the bedside with definitive studies of CoQ10 in human cancer patients, publishing their results in 2007.29,30 They began their work with the established observation that it is the tumor metastasis, not the primary cancer, which is the cause of death in breast cancer patients. Find a way to prevent metastasis or at least slow its progression, the researchers reasoned, and one might dramatically improve outcomes for breast cancer sufferers. To test their hypothesis, they conducted two studies among a group of 84 breast cancer patients, randomly assigning them to receive a placebo or daily supplements with 100 mg CoQ10, 10 mg riboflavin, and 50 mg niacin. All patients were treated with tamoxifen as the primary chemotherapy drug as well. In the first study, the researchers measured tumor markers, the blood proteins that reflect the degree to which a tumor has progressed and potentially spread.29 Once treated with tamoxifen, levels of tumor markers dropped significantly, as was expected. But patients treated with the CoQ10-containing supplement had still larger decreases in their tumor marker levels. From this work, the researchers concluded that the CoQ10-containing supplement “reduces… the risk of cancer recurrence and metastases.”
Not content with examining just one measure (tumor markers) of the effects of supplementation, the research group proceeded to examine the ways in which supplementation affected the various immune and tumor regulation system components that can contribute to the spread of cancer.30 Focusing on cytokines, the potent inter- and intracellular chemicals that signal inflammation and promote or allow the spread of cancer, the researchers obtained blood samples from the same 84 patients in the previous study. They also measured levels of vascular endothelial growth factor (VEGF), a tumor-promoting protein that cancer cells use to grow blood vessels. Lowering levels of all of these tumor-enhancing chemicals is a crucial step in slowing or preventing tumor spread. Again, the results were unambiguous—supplemented [CoQ10, riboflavin, and niacin] patients had significantly reduced levels of all the cytokines and VEGF, compared with those treated with tamoxifen only. Powerfully, the scientists concluded that, “such a decrease in serum cytokine levels after [CoQ10, riboflavin, and niacin] supplementation in breast cancer patients may suggest good prognosis and efficacy of the treatment, and might even offer protection from metastases and recurrence of cancer.” These dramatic findings all point to CoQ10’s versatile immune-enhancing and tumor-reducing powers in breast cancer. But what about other, even more resistant cancers? Given the vital role of the immune system in keeping patients cancer-free after treatment of all kinds of tumors, researchers in Rome studied immune-boosting treatments for patients with one of the most deadly and treatment-resistant cancers, malignant melanoma.31 Early and aggressive surgery has been the mainstay of treatment for this deadly form of skin cancer.32 The addition of treatment with immune-boosting cytokines such as interferon-alpha and interleukin-2 has slightly improved survival but at the cost of significant side effects.33 The Rome researchers had noted that melanoma patients have low levels of CoQ10, and reasoned that the addition of the nutrient to interferon therapy might enhance its success while reducing side effects. They conducted a three-year trial of uninterrupted treatment with low-dose interferon-alpha only, or with the addition of 400 mg/day of CoQ10 in patients with early melanoma following surgical removal of the tumors. They followed the patients all the way out to 5 years following treatment. Remarkably for such a lengthy study, no patient withdrew from the trial as a result of side effects. Most importantly, the disease progressed much more slowly in the interferon plus CoQ10-treated patients, who also had a significantly reduced rate of recurrence of the tumors than the unsupplemented group.31
One of the reasons that cytokine levels are elevated in cancer patients is the powerful inflammatory response produced in normal tissues by the tumor—and, as we’ve seen, the inflammatory response is itself involved in the growth and spread of new tumor tissues. Unfortunately, many cancer chemotherapy agents produce inflammation, often as a result of the intentional oxidant damage they inflict on tumor cells and their components. Despite its beneficial effects in the treatment of breast cancer, tamoxifen is notorious for imposing oxidative stress and increasing markers of inflammation. It also disrupts patients’ lipid profiles, elevating low-density lipoprotein (LDL), triglycerides, and total cholesterol, while lowering the protective high-density lipoprotein (HDL). The Madras research group therefore set out to determine how CoQ10 affects antioxidant status and lipid profiles, reasoning that some of its benefit might be the result of restoring balance to these fundamental parameters.34,35 Not surprisingly, untreated breast cancer patients were found to have increased lipid levels and elevated levels of inflammatory oxidized fats. Treatment with tamoxifen had only a limited impact on oxidative stress, and also induced a severe elevation of triglycerides (fat molecules) in the patients’ serum. When the researchers added CoQ10, riboflavin, and niacin supplementation, however, levels of oxidized fats fell dramatically, with a concomitant increase in antioxidant levels.34 Remarkably, the tamoxifen-induced disruptions in the lipid profiles also responded to CoQ10 combination therapy. All of the lipid profile abnormalities reverted to near-normal levels after 90 days of treatment with the combination (tamoxifen plus CoQ10 and other nutrients) therapy.35
SummaryPerhaps even more feared than the diagnosis of cancer itself are the horrendous side effects associated with chemotherapy. New discoveries show that coenzyme Q10 not only helps prevent healthy cells from undergoing malignant changes, but also protects against chemotherapy side effects and inflammatory damage inflicted on the body by cancer cells. Coenzyme Q10 celebrated the 50th anniversary of its discovery in 2007. For most of its “lifetime” in human biology, it has been seen only as a nutrient related to cellular energy metabolism and has therefore been best known for its beneficial effects on heart muscle and brain tissue.36,37 In recent years, CoQ10 has found vast new roles in maintaining health and prolonging life. • If you have any questions on the scientific content of this article, please call a Life Extension Health Advisor at 1-800-226-2370. | |||||
| References | |||||
| 1. Siemieniuk E, Skrzydlewska E. Coenzyme Q10: its biosynthesis and biological significance in animal organisms and in humans. Postepy Hig Med Dosw.(Online). 2005;59:150-9. 2. Ross D, Kepa JK, Winski SL, et al. NAD(P)H:quinone oxidoreductase 1 (NQO1): chemoprotection, bioactivation, gene regulation and genetic polymorphisms. Chem Biol Interact. 2000 Dec 1;129(1-2):77-97. 3. Dlugosz A, Sawicka E. The chemoprotective effect of coenzyme Q on lipids in the paint and lacquer industry workers. Int J Occup Med Environ Health. 1998;11(2):153-63. 4. Ross D. Quinone reductases multitasking in the metabolic world. Drug Metab Rev. 2004 Oct;36(3-4):639-54. 5. Ratnam DV, Ankola DD, Bhardwaj V, Sahana DK, Kumar MN. Role of antioxidants in prophylaxis and therapy: A pharmaceutical perspective. J Control Release. 2006 Jul 20;113(3):189-207. 6. Combs AB, Choe JY, Truong DH, Folkers K. Reduction by coenzyme Q10 of the acute toxicity of adriamycin in mice. Res Commun Chem Pathol Pharmacol. 1977 Nov;18(3):565-8. 7. Wallace KB. Adriamycin-induced interference with cardiac mitochondrial calcium homeostasis. Cardiovasc Toxicol. 2007;7(2):101-7. 8. Iarussi D, Auricchio U, Agretto A, et al. Protective effect of coenzyme Q10 on anthracyclines cardiotoxicity: control study in children with acute lymphoblastic leukemia and non-Hodgkin lymphoma. Mol Aspects Med. 1994;15 Suppl:s207-12. 9. Dobrovolskaia MA, Kozlov SV. Inflammation and cancer: when NF-kappaB amalgamates the perilous partnership. Curr Cancer Drug Targets. 2005 Aug;5(5):325-44. 10. Perumal SS, Shanthi P, Sachdanandam P. Combined efficacy of tamoxifen and coenzyme Q10 on the status of lipid peroxidation and antioxidants in DMBA induced breast cancer. Mol Cell Biochem. 2005 May;273(1-2):151-60. 11. Bubici C, Papa S, Dean K, Franzoso G. Mutual cross-talk between reactive oxygen species and nuclear factor-kappa B: molecular basis and biological significance. Oncogene. 2006 Oct 30;25(51):6731-48. 12. Papa S, Bubici C, Zazzeroni F, et al. The NF-kappaB-mediated control of the JNK cascade in the antagonism of programmed cell death in health and disease. Cell Death Differ. 2006 May;13(5):712-29. 13. Okada K, Yamada S, Kawashima Y, et al. Cell injury by antineoplastic agents and influence of coenzyme Q10 on cellular potassium activity and potential difference across the membrane in rat liver cells. Cancer Res. 1980 May;40(5):1663-7. 14. Kawase I, Niitani H, Saijo N, Sasaki H, Morita T. Enhancing effect of coenzyme, Q10 on immunorestoration with Mycobacterium bovis BCG in tumor-bearing mice. Gann. 1978 Aug;69(4):493-7. 15. Niitani H, Kawase I, Taniguchi T, Saijo N, Irimajiri N. Combined effect of BCG and coenzyme Q10 on ATP-ase activity and coenzyme Q content in spleen lymphocytes of tumor-bearing rats. Gann. 1979 Jun;70(3):315-22. 16. Kokawa T, Shiota K, Oda K, et al. Coenzyme Q10 in cancer chemotherapy—experimental studies on augmentation of the effects of masked compounds, especially in the combined chemotherapy with immunopotentiators. Gan To Kagaku Ryoho. 1983 Mar;10(3):768-74. 17. Suzuki H, Yamamoto J, Iwata Y, Matsumoto K, Iriyama K. Effects of immunostimulation with OK432, coenzyme Q10, or levamisole on dimethylhydrazine-induced colonic carcinogenesis in rats. Jpn J Surg. 1986 Mar;16(2):152-5. 18. Folkers K, Brown R, Judy WV, Morita M. Survival of cancer patients on therapy with coenzyme Q10. Biochem Biophys Res Commun. 1993 Apr 15;192(1):241-5. 19. Folkers K, Osterborg A, Nylander M, Morita M, Mellstedt H. Activities of vitamin Q10 in animal models and a serious deficiency in patients with cancer. Biochem Biophys Res Commun. 1997 May 19;234(2):296-9. 20. Hodges S, Hertz N, Lockwood K, Lister R. CoQ10: could it have a role in cancer management? Biofactors. 1999;9(2-4):365-70. 21. Perumal SS, Shanthi P, Sachdanandam P. Energy-modulating vitamins—a new combinatorial therapy prevents cancer cachexia in rat mammary carcinoma. Br J Nutr. 2005 Jun;93(6):901-9. 22. Sakano K, Takahashi M, Kitano M, Sugimura T, Wakabayashi K. Suppression of azoxymethane-induced colonic premalignant lesion formation by coenzyme Q10 in rats. Asian Pac J Cancer Prev. 2006 Oct;7(4):599-603. 23. Perumal SS, Shanthi P, Sachdanandam P. Augmented efficacy of tamoxifen in rat breast tumorigenesis when gavaged along with riboflavin, niacin, and CoQ10: effects on lipid peroxidation and antioxidants in mitochondria. Chem Biol Interact. 2005 Feb 28;152(1):49-58. 24. Faloon W. As We See It: CoQ10 and Cancer. Life Extension. Feb, 2006:7-10. 25. Akihama T, Nakamoto Y, Shindo T, Nakayama Y, Miura A. Protective effects of coenzyme Q10 on the adverse reactions of anthracycline antibiotics: using double blind method—with special reference to hair loss. Gan To Kagaku Ryoho. 1983 Oct;10(10):2125-9. 26. Folkers K, Morita M, McRee J, Jr. The activities of coenzyme Q10 and vitamin B6 for immune responses. Biochem Biophys Res Commun. 1993 May 28;193(1):88-92. 27. Lockwood K, Moesgaard S, Hanioka T, Folkers K. Apparent partial remission of breast cancer in ‘high risk’ patients supplemented with nutritional antioxidants, essential fatty acids and coenzyme Q10. Mol Aspects Med. 1994;15 Suppl:s231-40. 28. Lockwood K, Moesgaard S, Folkers K. Partial and complete regression of breast cancer in patients in relation to dosage of coenzyme Q10. Biochem Biophys Res Commun. 1994 Mar 30;199(3):1504-8. 29. Premkumar VG, Yuvaraj S, Vijayasarathy K, Gangadaran SG, Sachdanandam P. Effect of coenzyme Q10, riboflavin and niacin on serum CEA and CA 15-3 levels in breast cancer patients undergoing tamoxifen therapy. Biol Pharm Bull. 2007 Feb;30(2):367-70. 30. Premkumar VG, Yuvaraj S, Vijayasarathy K, Gangadaran SG, Sachdanandam P. Serum cytokine levels of interleukin-1beta, -6, -8, tumour necrosis factor-alpha and vascular endothelial growth factor in breast cancer patients treated with tamoxifen and supplemented with co-enzyme Q(10), riboflavin and niacin. Basic Clin Pharmacol Toxicol. 2007 Jun;100(6):387-91. 31. Rusciani L, Proietti I, Paradisi A, et al. Recombinant interferon alpha-2b and coenzyme Q10 as a postsurgical adjuvant therapy for melanoma: a 3-year trial with recombinant interferon-alpha and 5-year follow-up. Melanoma Res. 2007 Jun;17(3):177-83. 32. Blazer DG, III, Sondak VK, Sabel MS. Surgical therapy of cutaneous melanoma. Semin Oncol. 2007 Jun;34(3):270-80. 33. Kalaaji AN. Cytokine therapy in advanced melanoma. J Drugs Dermatol. 2007 Apr;6(4):374-8. 34. Yuvaraj S, Premkumar VG, Vijayasarathy K, Gangadaran SG, Sachdanandam P. Augmented antioxidant status in Tamoxifen treated postmenopausal women with breast cancer on co-administration with Coenzyme Q(10), Niacin and Riboflavin. Cancer Chemother Pharmacol. 2007 Aug 1. 35. Yuvaraj S, Premkumar VG, Vijayasarathy K, Gangadaran SG, Sachdanandam P. Ameliorating effect of coenzyme Q10, riboflavin and niacin in tamoxifen-treated postmenopausal breast cancer patients with special reference to lipids and lipoproteins. Clin Biochem. 2007 Jun;40(9-10):623-8. 36. Singh U, Devaraj S, Jialal I. Coenzyme Q10 supplementation and heart failure. Nutr Rev. 2007 Jun;65(6 Pt 1):286-93. 37. Galpern WR, Cudkowicz ME. Coenzyme Q treatment of neurodegenerative diseases of aging. Mitochondrion. 2007 Jun;7 Suppl:S146-53. 38. Hosoe K, Kitano M, Kishida H, Kubo H, Fujii K, Kitahara M. Study on safety and bioavailability of ubiquinol (Kaneka QH(trade mark)) after single and 4-week multiple oral administration to healthy volunteers. Regul Toxicol Pharmacol. 2007 Feb;47(1):19-28. 39. Shults CW, Oakes D, Kieburtz K, et al. Effects of coenzyme Q10 in early Parkinson disease: evidence of slowing of the functional decline. Arch Neurol. 2002 Oct;59(10):1541-50. 40. Shults CW, Flint BM, Song D, Fontaine D. Pilot trial of high dosages of coenzyme Q10 in patients with Parkinson’s disease. Exp Neurol. 2004 Aug;188(2):491-4. |